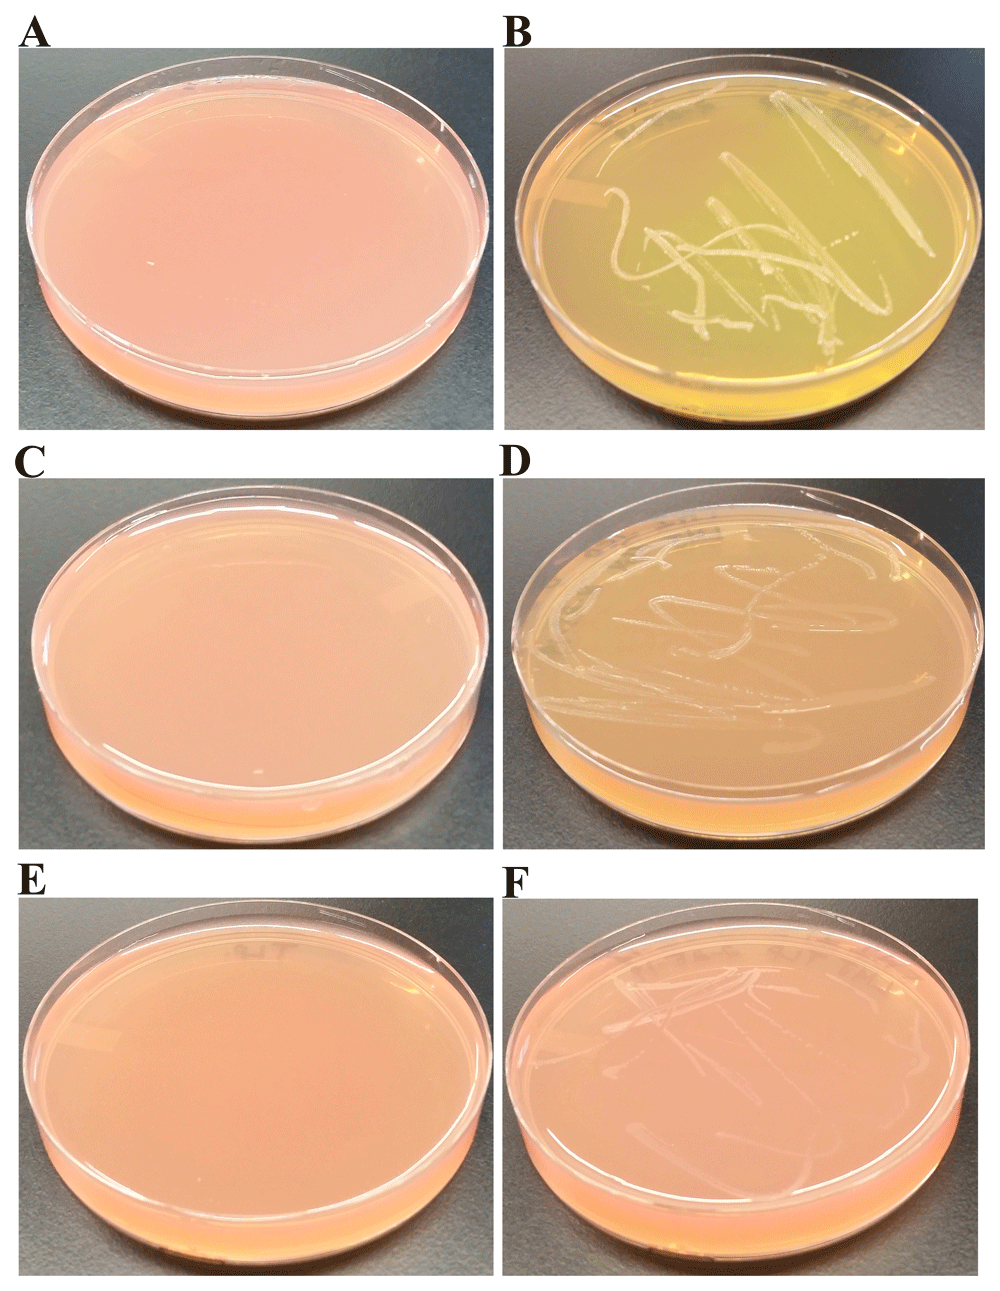

Msa Plate Test

Mannitol Salt Agar Msa For The Identification Of Staphylococcus Aureus And Epidermidis

Mannitol Salt Agar Plate Test Composition Preparation Uses Laboratoryinfo Com

Mannitol Salt Agar Plate Test Composition Preparation Uses Laboratoryinfo Com

Macconkey Agar Youtube

Mannitol Salt Agar Msa Composition Uses And Colony Characteristics Learn Microbiology Online
Q Tbn 3aand9gctnx Wecq2e2d59exdiacpnnfhbzsbiv1pnvq5ncxdno8cfthsy Usqp Cau


Lab Manual Superfarmer S Weblog

Experiment 8c Lab08 Virtual Edge Molb 21 College Of Agriculture And Natural Sciences
1
Isolation And Characterization Of A Novel Bacterial F1000research

Mannitol Salt Agar Msa Plate
Www Studocu Com En Us Document College Of Marin Kentfield Microbiology Summaries Microbio Lab Exam 2 Review View

Msa Emb Mac Media Youtube

Bacillus Subtilis Soil Project Microbewiki

Welcome To Adobe Golive 4
Jcm Asm Org Content Jcm 38 6 2378 Full Text Pdf

Solved 7 Below Is An Msa Plate Inoculated With Bacteria Chegg Com

Microbio 225 Lab Test 3 Selective And Differential Media Imvic Biochem Tests With Some Bacterial Samples Flashcards Questions And Answers Quizlet

Mannitol Salt Agar Msa Test Scientist Cindy

Hardy Diagnostics Mannitol Salt Agar Msa Usp For Staphylococcus 15x100mm Plate Order By The Package Of 10 Science Lab Agar Media Amazon Com Industrial Scientific

Mannitol Salt Agar Microbiology Images Photographs From Science Prof Online
Q Tbn 3aand9gcq1d7hg4azo7wdzwbrpugcgxr3hzi05irgmcidtbjrvj0afxub2 Usqp Cau

Vetbact

Welcome To Microbugz Mannitol Salt Agar

Microbiology Lab Molb 2210

Selective Growth Of Staphylococcus Aureus From Flushed Dairy Manure Wastewater Using Acriflavine Supplemented Mannitol Salt Agar Davis 06 Letters In Applied Microbiology Wiley Online Library

Solved Mannitol Salts Agar Msa Ex 4 4 13 What Is The Chegg Com

Welcome To Microbugz Macconkey Agar

Biol 230 Lab Manual Lab 15

Msa Plate You Ll Remember Quizlet

Asmscience Mannitol Salt Agar Plates Protocols

Biochemical Test And Identification Of Enterococcus Faecalis

Microbiology Lab Molb 2210

Pathogenic Bacteria And Identification Microbiology Learning The Why Ology Of Microbial Testing

When The Professor Says You Can Swab Anything For Your Msa Plate Microbiology

Lab 12 Staphylococcus And Streptococcus Biology Libretexts
Solved Mannitol Salts Agar Msa Ex 4 4 13 What Is The Chegg Com

Mannitol Salt Agar Msa Composition Uses And Colony Characteristics Learn Microbiology Online

Solved Test Results For Isolate 1 Msa Plate Glucose Br Chegg Com

Selective And Diff Media List

Pseudomonas Aeruginosa Morphology Growth Characteristics And Microscopic Appearance Of P Aerginosa Images Of Pseudomonas Aeruginosa Infections Caused By Pseudomonas Aeruginosa

Mannitol Salt Bacterial Growth Medium Msa Page 2

Alcaligenes Faecalis Grade B Rc 101 Liu Studocu

Salmonella And Salmonellosis

Mannitol Salt Bacterial Growth Medium Msa Page 2

I Ve Attached Lab Worksheets And Images Phenylet Chegg Com

Mannitol Salt Agar Msa Test Scientist Cindy

A Dream Within A Dream Mannitol Salt Agar Test For Bacillus Subtilis

Metabolism Physiology And Growth Characteristics Of Cocci Microbiology A Laboratory Experience

Mannitol Salt Bacterial Growth Medium Msa Page 2

Micro Lab Flashcards Chegg Com

Experiment 8c Lab08 Virtual Edge Molb 21 College Of Agriculture And Natural Sciences

Welcome To Microbugz Blood Agar Test
Http Www Mccc Edu Hilkerd Documents Bio1lab9 Exp13 14 17 18 19 001 Pdf

Mannitol Salt Agar Msa Results Theory Youtube

Mannitol Salt Agar Test Msa Flashcards Quizlet

Summary Of Bi 101j Gen Bio Unseen Life On Earth Su Stearns

Mannitol Salt Agar Microbiology Images Photographs From Science Prof Online
Http Www Interchim Fr Ft J Jh992a Pdf

Mannitol Salt Agar Wikipedia

Ilovemicrobiology Ilana Kovach
Www Jfmed Uniba Sk Fileadmin Jlf Pracoviska Ustav Mikrobiologie A Imunologie Vla Staphylococci Pdf

What Is Mannitol Salt Agar Biology Wise

How To Interpret Mannitol Salt Agar Bacterial Growth Medium Youtube

Klebsiella Pneumoniae Colony Morphology And Microscopic Appearance Basic Characteristic And Tests For Identification Of Klebsiella Pneumoniae Bacteria Images Of K Pneumoniae Klebsiella Peumoniae Treatment And Antibiotics Used For K Pneumoniae

Mannitol Salt Agar Plate Test Composition Preparation Uses Laboratoryinfo Com

Mannitol Salt Agar Microbiology Images Photographs From Science Prof Online

Mannitol Salt Agar For The Isolation Of Staphylococcus Aureus

Lab 5 Integumentary System Bacteriology And Identification Ppt Download

Mannitol Salt Bacterial Growth Medium Msa Page 2
Link Springer Com Content Pdf 10 1007 S 012 11 5 Pdf

Metabolism Physiology And Growth Characteristics Of Cocci Microbiology A Laboratory Experience
Nanopdf Com Download Ex 13 Selective Media For Isolating Gram Pdf

Macconkey Agar Wikipedia

Vetbact

Solved After Observing The Results From Your Blood Agar P Chegg Com

Mannitol Salt Agar Plate Test Composition Preparation Uses Laboratoryinfo Com

Thermo Scientific Remel Mannitol Salt Agar Msa Mannitol Salt Agar Spacesaver Fisher Scientific

Harpactirinae Biotechnology Microbes Theoretical Result Part 2 Microbiology Lab Microbiology Medical Laboratory Scientist

6 3c Selective And Differential Media Biology Libretexts
Bam Chapter 14 Bacillus Cereus Fda

Mannitol Salt Agar Msa For The Identification Of Staphylococcus Aureus And Epidermidis

Msa Plate You Ll Remember Quizlet

Mannitol Salt Agar Msa Plate

Hardy Diagnostics Mannitol Salt Agar Msa Usp For Staphylococcus 15x100mm Plate Order By The Package Of 10 Science Lab Agar Media Amazon Com Industrial Scientific

Mannitol Salt Agar Msa Test Scientist Cindy

Hardy Diagnostics Mannitol Salt Agar Msa Usp For Staphylococcus 15x100mm Plate Order By The Package Of 10 Science Lab Agar Media Amazon Com Industrial Scientific

Mannitol Salt Agar Msa Composition Uses And Colony Characteristics Learn Microbiology Online

Staphylococcus Aureus And Staphylococcus Epidermidis On Mannitol Salt Agar Mannitol Salt Agar Composition Positive And Negative Result On Mannitol Salt Agar
Www Jfmed Uniba Sk Fileadmin Jlf Pracoviska Ustav Mikrobiologie A Imunologie Vla Staphylococci Pdf

Skills In Medical Microbiology

Media Used For Bacterial Growth Microbiology

Microbio 225 Lab Test 3 Selective And Differential Media Imvic Biochem Tests With Some Bacterial Samples Flashcards Questions And Answers Quizlet
Www Com Documents Legacy Brochures Microbiology Solutions Prepared Culture Media Ds Pm l Prepared Plated Media Br En Pdf

9 Tips For Growth Promotion Testing On Selective Media Microbiologics Blog

Culture Media Microbiology Resource Center Truckee Meadows Community College

Mannitol Salt Agar Msa Test Scientist Cindy
1
Biol 230 Lab Manual Staphylococcus Epidermidis On Mannitol Salt Agar

Selective And Differential Media Ppt Video Online Download

Microbiology Lab Molb 2210

Mannitol Salt Agar Msa Test Superfarmer S Weblog

Mannitol Salt Bacterial Growth Medium Msa

Staphylococcus Identification Tests Ppt Video Online Download